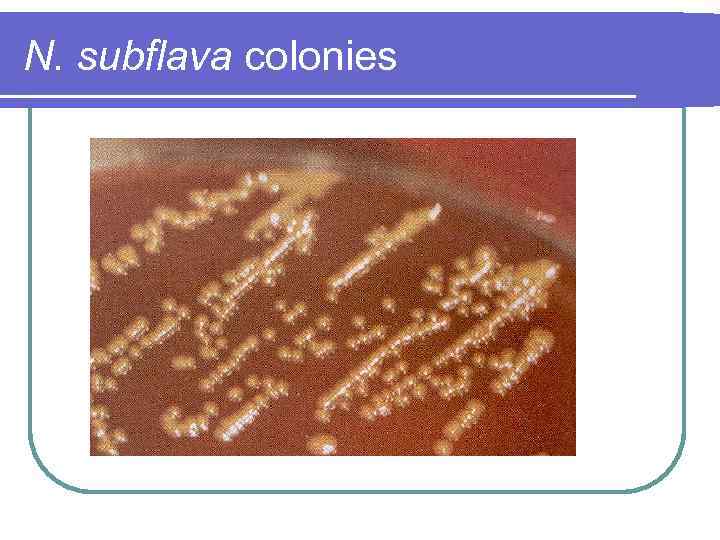
N. subflava colonies
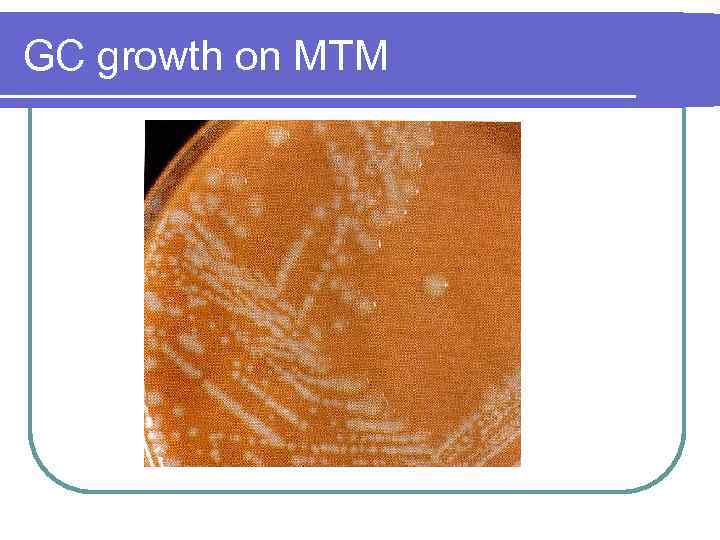
GC growth on MTM
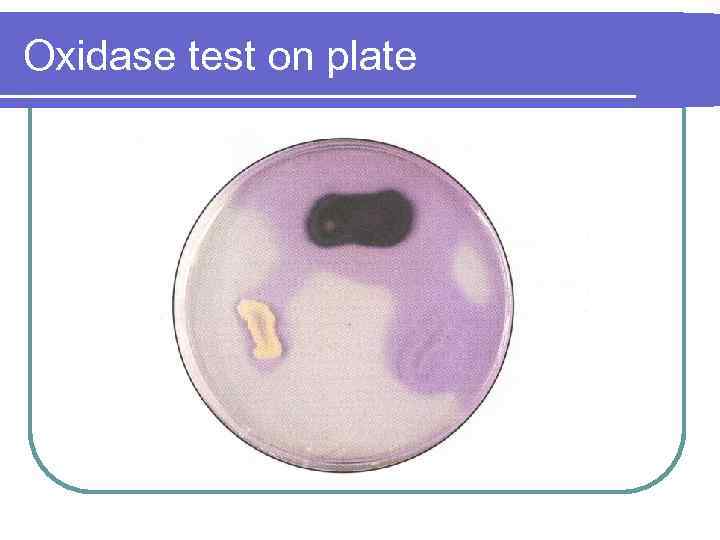
Oxidase test on plate

Lec 4 Neisseriaceae.ppt
- Количество слайдов: 48
 Neisseriaceae The Gram negative cocci of clinical importance
Neisseriaceae The Gram negative cocci of clinical importance
 Neisseriaceae l Classification Family Neisseriaceae are all Gram negative aerobic rods and cocci. Contains 4 genera: Neisseria cocci l Moraxella, subgenus Branhamella cocci; other species within the genus are short rods l Acinetobacter rods l Kingella rods l
Neisseriaceae l Classification Family Neisseriaceae are all Gram negative aerobic rods and cocci. Contains 4 genera: Neisseria cocci l Moraxella, subgenus Branhamella cocci; other species within the genus are short rods l Acinetobacter rods l Kingella rods l
 Neisseriaceae We will only be discussing Neisseria and Branhamella which morphologically and biochemically resembles Neisseria, but shows DNA homology to Moraxella. l Some are found as part of the normal flora of the naso and oropharynx and are usually considered to be non pathogenic. l Two species N. meningitidis (MGC) and N. gonorrhoeae (GC) are considered to be pathogenic although N. meningitidis may be found as part of the nasopharynx normal flora in 10 15% of the population. l
Neisseriaceae We will only be discussing Neisseria and Branhamella which morphologically and biochemically resembles Neisseria, but shows DNA homology to Moraxella. l Some are found as part of the normal flora of the naso and oropharynx and are usually considered to be non pathogenic. l Two species N. meningitidis (MGC) and N. gonorrhoeae (GC) are considered to be pathogenic although N. meningitidis may be found as part of the nasopharynx normal flora in 10 15% of the population. l
 Neisseria and Branhamella l Morphology and General Characteristics Gram negative diplococci that are coffee bean shaped with adjacent flattened edges. l In a direct smear GC may be found intracellularly in PMNs or extracellularly. l
Neisseria and Branhamella l Morphology and General Characteristics Gram negative diplococci that are coffee bean shaped with adjacent flattened edges. l In a direct smear GC may be found intracellularly in PMNs or extracellularly. l
 Neisseria species Gram stain
Neisseria species Gram stain
 Intracellular GC
Intracellular GC
 Morphology and General Characteristics l l B. catarrhalis and Neisseria species other than MGC and GC will grow on nutrient agar without blood. MGC and GC are more fastidious and require serum or blood in addition to other growth factors. l l l GC is more fastidious and requires chocolate agar, whereas MGC may grow on CBA. Colonies of both are small and translucent to grayish white. Colonies of non pathogenic species may be dry and wrinkled, opaque or yellow, and they tend to be self adherent.
Morphology and General Characteristics l l B. catarrhalis and Neisseria species other than MGC and GC will grow on nutrient agar without blood. MGC and GC are more fastidious and require serum or blood in addition to other growth factors. l l l GC is more fastidious and requires chocolate agar, whereas MGC may grow on CBA. Colonies of both are small and translucent to grayish white. Colonies of non pathogenic species may be dry and wrinkled, opaque or yellow, and they tend to be self adherent.
 MGC colonies
MGC colonies
 N. sicca colonies
N. sicca colonies
N. subflava colonies
N. subflava colonies
 Morphology and General Characteristics l A selective media is usually used to recover MGC and GC when the specimen is likely to be contaminated with other bacterial normal flora. l Modified Thayer Martin (MTM) is the most common of these. l l It is chocolate agar containing Vancomycin (inhibits G +), Colistin (inhibits G ), Nystatin (inhibits fungi), and Trimethoprim (inhibits swarming Proteus). Occasional strains of GC are sensitive to Vancomycin, therefore, both chocolate agar and MTM should always be used. The colonies may require 48 72 hours for growth. Lewis Martin agar is similar to MTM, but it has anisomycin substituted for nystatin for improved inhibition of Candida albicans.
Morphology and General Characteristics l A selective media is usually used to recover MGC and GC when the specimen is likely to be contaminated with other bacterial normal flora. l Modified Thayer Martin (MTM) is the most common of these. l l It is chocolate agar containing Vancomycin (inhibits G +), Colistin (inhibits G ), Nystatin (inhibits fungi), and Trimethoprim (inhibits swarming Proteus). Occasional strains of GC are sensitive to Vancomycin, therefore, both chocolate agar and MTM should always be used. The colonies may require 48 72 hours for growth. Lewis Martin agar is similar to MTM, but it has anisomycin substituted for nystatin for improved inhibition of Candida albicans.
GC growth on MTM
GC growth on MTM
 Morphology and General Characteristics Members of the genus Neisseria and B. catarrhalis are aerobic with little or no growth under anaerobic conditions. l MGC and GC require a CO 2 concentration of 3 10% for growth, particularly for primary isolation. l In the lab we will be growing the Neisseria in candle jars. l
Morphology and General Characteristics Members of the genus Neisseria and B. catarrhalis are aerobic with little or no growth under anaerobic conditions. l MGC and GC require a CO 2 concentration of 3 10% for growth, particularly for primary isolation. l In the lab we will be growing the Neisseria in candle jars. l
 Growth in candle jars
Growth in candle jars
 Morphology and General Characteristics l l GC and MGC are particularly sensitive to temperature extremes and drying, therefore successful cultivation depends upon careful collection and careful processing of specimens. Ideally, specimens should be plated directly onto culture media and incubated immediately. l l The reason for this is that MGC and GC may produce autolytic enzymes at 250 C and an alkaline p. H leading to lysis of the cells. Most MGC and GC produce capsules.
Morphology and General Characteristics l l GC and MGC are particularly sensitive to temperature extremes and drying, therefore successful cultivation depends upon careful collection and careful processing of specimens. Ideally, specimens should be plated directly onto culture media and incubated immediately. l l The reason for this is that MGC and GC may produce autolytic enzymes at 250 C and an alkaline p. H leading to lysis of the cells. Most MGC and GC produce capsules.
 Neisseria and Branhamella l Biochemical identification need to distinguish between B. catarrhalis and both pathogenic and non pathogenic Neisseria. l To distinguish from other organisms – use colony morphology l Gram stain (g dc), and l the fact that it is catalase and oxidase positive. l
Neisseria and Branhamella l Biochemical identification need to distinguish between B. catarrhalis and both pathogenic and non pathogenic Neisseria. l To distinguish from other organisms – use colony morphology l Gram stain (g dc), and l the fact that it is catalase and oxidase positive. l
Oxidase test on plate
Oxidase test on plate
 Oxidase test on paper
Oxidase test on paper
 Biochemical identification l To differentiate between the different Neisseria species and B. catarrhalis. l Carbohydrate utilization tests These are not fermentation tests because the organisms use carbohy drates oxidatively. l l Cystine tryptic agar (CTA) sugars are the reference tests, but require a heavy inoculation, incubation in a non CO 2 incubator and observation for 24 72 hours. Some fastidious GC won't grow or grow very poorly on CTA and the small amount of acid produced is neutralized by alkaline products formed from peptone utilization. The sugars glucose, maltose, lactose, sucrose and fructose are commonly used. Pertinent results: GC + for glucose only; MGC + for glucose and maltose; B. catarrhalis for all.
Biochemical identification l To differentiate between the different Neisseria species and B. catarrhalis. l Carbohydrate utilization tests These are not fermentation tests because the organisms use carbohy drates oxidatively. l l Cystine tryptic agar (CTA) sugars are the reference tests, but require a heavy inoculation, incubation in a non CO 2 incubator and observation for 24 72 hours. Some fastidious GC won't grow or grow very poorly on CTA and the small amount of acid produced is neutralized by alkaline products formed from peptone utilization. The sugars glucose, maltose, lactose, sucrose and fructose are commonly used. Pertinent results: GC + for glucose only; MGC + for glucose and maltose; B. catarrhalis for all.
 CTA sugars
CTA sugars
 Biochemical identification l We now have non growth dependent tests which depend on preformed enzymes. l l l Kits are now available that can identify the different organisms by using enzyme profiles obtained using chromogenic substrates. l l A heavy inoculation of organism is used with a small volume of carbohydrate in a buffered salt solution. Results are read in 4 hours. Results are in 4 hours and are non growth dependent. This is what we will do in the lab. DNAse test B. catarrhalis is + for DNAse , all Neisseria are . Nitrate reduction GC and MGC are for nitrate reduction, B. catarrhalis is +. l Some nonpathogenic Neisseria species are + and others are -.
Biochemical identification l We now have non growth dependent tests which depend on preformed enzymes. l l l Kits are now available that can identify the different organisms by using enzyme profiles obtained using chromogenic substrates. l l A heavy inoculation of organism is used with a small volume of carbohydrate in a buffered salt solution. Results are read in 4 hours. Results are in 4 hours and are non growth dependent. This is what we will do in the lab. DNAse test B. catarrhalis is + for DNAse , all Neisseria are . Nitrate reduction GC and MGC are for nitrate reduction, B. catarrhalis is +. l Some nonpathogenic Neisseria species are + and others are -.
 Neisseria and Branhamella l Serologic and Other Identification methods – l l Many kits are available for serologic identification of MGC and GC Auxotyping distinguishes GC on the basis of nutritional requirements. l l Gonococcal strains that are associated with disseminated disease have a multiple requirement for arginine, hypoxanthine and uracil. Nucleic acid based tests – both probe based and PCR based tests have been developed for the identification of GC directly from clinical samples.
Neisseria and Branhamella l Serologic and Other Identification methods – l l Many kits are available for serologic identification of MGC and GC Auxotyping distinguishes GC on the basis of nutritional requirements. l l Gonococcal strains that are associated with disseminated disease have a multiple requirement for arginine, hypoxanthine and uracil. Nucleic acid based tests – both probe based and PCR based tests have been developed for the identification of GC directly from clinical samples.
 Neisseria and Branhamella l Mechanisms of Pathogenicity – l Neisseria gonorrhoeae – l l l Pili important in attachment to human columnar epithelial cells may inhibit phagocytosis. Protein I (Por) the principal protein found on the outer membrane functions as a porin to allow small molecules to diffuse thru the membrane and is important for intracellular survival. l Is protective against host’s inflammatory response and serum complement mediated killing Protein II (Opa) a minor protein found on the outer membrane. l It is involved in attachment to PMNs and other leukocytes where it induces the endocytic uptake of GC l After endocytosis, GC is transported in vesicles to the base of the cells and released into subepithelial tissue. l Both pili and protein II are subject to antigenic variation; even if antibodies are formed against them they are not effective.
Neisseria and Branhamella l Mechanisms of Pathogenicity – l Neisseria gonorrhoeae – l l l Pili important in attachment to human columnar epithelial cells may inhibit phagocytosis. Protein I (Por) the principal protein found on the outer membrane functions as a porin to allow small molecules to diffuse thru the membrane and is important for intracellular survival. l Is protective against host’s inflammatory response and serum complement mediated killing Protein II (Opa) a minor protein found on the outer membrane. l It is involved in attachment to PMNs and other leukocytes where it induces the endocytic uptake of GC l After endocytosis, GC is transported in vesicles to the base of the cells and released into subepithelial tissue. l Both pili and protein II are subject to antigenic variation; even if antibodies are formed against them they are not effective.
 Induced uptake
Induced uptake
 Neisseria and Branhamella l Protein III (rmp) – an outer membrane protein that may associate with Protein I to form pores. l l Blocks host serum bacteriocidal (Ig. G) action against the organism by eliciting formation of blocking antibodies Lipopooligosaccharide (LOS) comparable to LPS of Gram negative bacilli (endotoxin). May undergo antigenic variation and causes mucous membrane damage, fever and toxicity. Specific activities include: l l l Adherence and invasion Molecular mimicry of host structures Release in membrane blebs Suppression of leukotreine B 4 synthesis→ inhibits PMN activation Activates alternative complement pathway → inflammation Activates TNF → inflammation
Neisseria and Branhamella l Protein III (rmp) – an outer membrane protein that may associate with Protein I to form pores. l l Blocks host serum bacteriocidal (Ig. G) action against the organism by eliciting formation of blocking antibodies Lipopooligosaccharide (LOS) comparable to LPS of Gram negative bacilli (endotoxin). May undergo antigenic variation and causes mucous membrane damage, fever and toxicity. Specific activities include: l l l Adherence and invasion Molecular mimicry of host structures Release in membrane blebs Suppression of leukotreine B 4 synthesis→ inhibits PMN activation Activates alternative complement pathway → inflammation Activates TNF → inflammation
 LOS and Membrane blebs
LOS and Membrane blebs
 Neisseria and Branhamella l l l Capsule – helps prevent phagocytosis and protects organism from antimicrobial peptides Ig. A 1 protease cleaves Ig. A to allow mucosal attachment of GC. Ability to acquire iron from the host by producing outer membrane proteins that capture it under conditions of iron limitation. l Enhanced capacity occurs in those that cause disseminated gonococcal infection (DGI).
Neisseria and Branhamella l l l Capsule – helps prevent phagocytosis and protects organism from antimicrobial peptides Ig. A 1 protease cleaves Ig. A to allow mucosal attachment of GC. Ability to acquire iron from the host by producing outer membrane proteins that capture it under conditions of iron limitation. l Enhanced capacity occurs in those that cause disseminated gonococcal infection (DGI).
 Iron acquisition
Iron acquisition
 GC cell wall structure
GC cell wall structure
 Neisseria and Branhamella l l Strains of GC that cause DGI possess certain types of Protein I, are resistant to phagocytosis and serum bactericidal activity, and are able to multiply unchecked in the presence of PMNs. Neisseria meningitidis – l Pili allow binding to specific nasopharyngeal receptors. l Type IV pili are essential for the interaction of MGC with brain endothelial cells
Neisseria and Branhamella l l Strains of GC that cause DGI possess certain types of Protein I, are resistant to phagocytosis and serum bactericidal activity, and are able to multiply unchecked in the presence of PMNs. Neisseria meningitidis – l Pili allow binding to specific nasopharyngeal receptors. l Type IV pili are essential for the interaction of MGC with brain endothelial cells
 Neisseria and Branhamella l Capsule (polysaccharide) – antibodies, if made, are protective. l l l l l Only certain serotype antigens are found during epidemics. Ability to acquire iron from human transferrin Ig. A 1 Protease Class 1, 2, and 3 outer membrane proteins ( Por) that function as porins and are important for intracellular survival Class 5 outer membrane protein (Opa) involved in attachment, induced uptake (invasion). Class 4 outer membrane protein (rmp) important in blocking host serum bacteriocidal (Ig. G) action against the organism by eliciting formation of blocking antibodies Opc protein – important for attachment and invasion LOS with same functions as GC LOS Pili, Opa, LOS, and to a lesser extent, Opc, undergo antigenic variation
Neisseria and Branhamella l Capsule (polysaccharide) – antibodies, if made, are protective. l l l l l Only certain serotype antigens are found during epidemics. Ability to acquire iron from human transferrin Ig. A 1 Protease Class 1, 2, and 3 outer membrane proteins ( Por) that function as porins and are important for intracellular survival Class 5 outer membrane protein (Opa) involved in attachment, induced uptake (invasion). Class 4 outer membrane protein (rmp) important in blocking host serum bacteriocidal (Ig. G) action against the organism by eliciting formation of blocking antibodies Opc protein – important for attachment and invasion LOS with same functions as GC LOS Pili, Opa, LOS, and to a lesser extent, Opc, undergo antigenic variation
 Neisseria and Branhamella l Clinical Significance – l Neisseria gonorrhoeae usually transmitted by direct sexual contact. l l l Used to be the most common reportable disease in the U. S. Those infected commonly have a concomitant Chlamydia trachomatis infection (most common reportable disease in the U. S. today). Asymptomatic infections Males= 10%, Females= 20 75%. l The problem with asymptomatic individuals is that they are carriers and can transmit the disease to others.
Neisseria and Branhamella l Clinical Significance – l Neisseria gonorrhoeae usually transmitted by direct sexual contact. l l l Used to be the most common reportable disease in the U. S. Those infected commonly have a concomitant Chlamydia trachomatis infection (most common reportable disease in the U. S. today). Asymptomatic infections Males= 10%, Females= 20 75%. l The problem with asymptomatic individuals is that they are carriers and can transmit the disease to others.
 Clinical significance of GC l Uncomplicated infections in males incubation= 1 4 days followed by acute urethritis with profuse purulent discharge filled with GC. l l If untreated may spread to cause prostitis and epididymitis with proper antibiotic treatment this is rare. With oropharyngeal infection mild pharyngitis. With rectal infection proctitis; Uncomplicated infections in females following the incubation may have increased vaginal discharge, burning or frequency of urination and menstrual abnormalities. l l Infected mothers can transmit GC to their babies at birth causing gonococcal ophthalmia neonatorum. This can lead to blindness, therefore all babies are given erythromycin eye drops at birth to prevent this.
Clinical significance of GC l Uncomplicated infections in males incubation= 1 4 days followed by acute urethritis with profuse purulent discharge filled with GC. l l If untreated may spread to cause prostitis and epididymitis with proper antibiotic treatment this is rare. With oropharyngeal infection mild pharyngitis. With rectal infection proctitis; Uncomplicated infections in females following the incubation may have increased vaginal discharge, burning or frequency of urination and menstrual abnormalities. l l Infected mothers can transmit GC to their babies at birth causing gonococcal ophthalmia neonatorum. This can lead to blindness, therefore all babies are given erythromycin eye drops at birth to prevent this.
 Uncomplicated GC infection Pus containing discharge
Uncomplicated GC infection Pus containing discharge
 Neonatal ophthalmia neonatorum
Neonatal ophthalmia neonatorum
 Clinical significance of GC l Complicated infections l Occur more frequently in women spread from the cervix into the fallopian tubes resulting in endometritis, salpingitis, and peritonitis= pelvic inflammatory disease (PID). l Occurs in 10 20% of infected women. l Symptoms include lower abdominal pain, abnormal vaginal and cervical discharge, and uterine tenderness. l This can result in ectopic pregnancy and infertility.
Clinical significance of GC l Complicated infections l Occur more frequently in women spread from the cervix into the fallopian tubes resulting in endometritis, salpingitis, and peritonitis= pelvic inflammatory disease (PID). l Occurs in 10 20% of infected women. l Symptoms include lower abdominal pain, abnormal vaginal and cervical discharge, and uterine tenderness. l This can result in ectopic pregnancy and infertility.
 Salpingitis
Salpingitis
 Complicated infections of GC l Spread to the bloodstream may result in DGI in both men and women (1%). l Can result in endocarditis, arthritis, maculopapular rash, and meningitis.
Complicated infections of GC l Spread to the bloodstream may result in DGI in both men and women (1%). l Can result in endocarditis, arthritis, maculopapular rash, and meningitis.
 Clinical significance l Neisseria meningitis causes endemic and epidemic cerebral meningitis. l l l l Most common in children under 1 year, adolescents, and young adults. Can be part of the normal flora of the nasopharynx and cause disease when there is a failure in host resistance or when a particularly virulent strain colonizes the mucous membranes. Asymptomatic carriers are the primary source of spread thru aerosols. Colonization of the nasopharynx usually results in a subclinical infection or a mild upper respiratory tract infection like the common cold. Invasion of the bloodstream occurs only in individuals lacking bactericidal antibodies or deficient in certain complement components (C 5 C 8). Chronic irritation or damage to the respiratory mucosa may be predisposing factors. Invasion of the bloodstream may result in septicemia (meningococcemia) or meningitis.
Clinical significance l Neisseria meningitis causes endemic and epidemic cerebral meningitis. l l l l Most common in children under 1 year, adolescents, and young adults. Can be part of the normal flora of the nasopharynx and cause disease when there is a failure in host resistance or when a particularly virulent strain colonizes the mucous membranes. Asymptomatic carriers are the primary source of spread thru aerosols. Colonization of the nasopharynx usually results in a subclinical infection or a mild upper respiratory tract infection like the common cold. Invasion of the bloodstream occurs only in individuals lacking bactericidal antibodies or deficient in certain complement components (C 5 C 8). Chronic irritation or damage to the respiratory mucosa may be predisposing factors. Invasion of the bloodstream may result in septicemia (meningococcemia) or meningitis.
 MGC infections l Meningococcemia symptoms include high fever, shaking, chills, muscle pain, and petechial rash (hallmark of MGC infections). l l Disease may be chronic, moderate or fulminant. The fulminant type is called the Waterhouse Friderichsen syndrome and it is characterized by disseminated intravascular coagulation (DIC), with hemorrhaging into the skin, adrenal glands and other internal organs. l This results in rapid death due to acute generalized toxemia and shock. l Most of these symptoms are due to the activity of the endotoxin (LOS). l Patients that survive may lose their limbs from tissue necrosis (gangrene of the skin and soft tissues)
MGC infections l Meningococcemia symptoms include high fever, shaking, chills, muscle pain, and petechial rash (hallmark of MGC infections). l l Disease may be chronic, moderate or fulminant. The fulminant type is called the Waterhouse Friderichsen syndrome and it is characterized by disseminated intravascular coagulation (DIC), with hemorrhaging into the skin, adrenal glands and other internal organs. l This results in rapid death due to acute generalized toxemia and shock. l Most of these symptoms are due to the activity of the endotoxin (LOS). l Patients that survive may lose their limbs from tissue necrosis (gangrene of the skin and soft tissues)
 Petechial rash
Petechial rash
 Waterhouse Friderichsen syndrome
Waterhouse Friderichsen syndrome
 Waterhouse Friderichsen syndrome
Waterhouse Friderichsen syndrome
 MGC infections l Meningitis symptoms include fever, headache, stiffness of back and neck, and petechial rash. l l l In severe cases there is severe cerebral hyperemia (accumulation of blood) and tissue swelling. May progress to convulsions and coma This is invariably fatal without rigorous antimicrobial therapy. 10% 14% of cases are fatal even with treatment For patients who recover 11% 19% have permanent hearing loss or mental retardation
MGC infections l Meningitis symptoms include fever, headache, stiffness of back and neck, and petechial rash. l l l In severe cases there is severe cerebral hyperemia (accumulation of blood) and tissue swelling. May progress to convulsions and coma This is invariably fatal without rigorous antimicrobial therapy. 10% 14% of cases are fatal even with treatment For patients who recover 11% 19% have permanent hearing loss or mental retardation
 Meningitis
Meningitis
 Clinical significance l l Other Neisseria species rarely associated with endocarditis, septicemia, and meningitis. B. catarrhalis may be a significant cause of otitis media and maxillary sinusitis in children l l May cause pneumonia and bronchitis in immunocompromised individuals. May also occasionally cause endocarditis, meningitis and septicemia.
Clinical significance l l Other Neisseria species rarely associated with endocarditis, septicemia, and meningitis. B. catarrhalis may be a significant cause of otitis media and maxillary sinusitis in children l l May cause pneumonia and bronchitis in immunocompromised individuals. May also occasionally cause endocarditis, meningitis and septicemia.
 Neisseriaceae l Treatment and antimicrobial susceptibility – l GC used to use only penicillin. l l Resistant strains are emerging so lactamase testing should be done. For penicillin resistant strains or penicillin sensitive individuals substitute ceftriaxone or spectinomycin for penicillin (1 dose to treat GC) plus 7 days of doxycycline to treat possible coexisting C. trachomatis infection. Amoxicillin or ampicillin or Penicillin G plus probenecid can be used for uncomplicated cases MGC I. V. penicillin or chloramphenicol and erythromycin or ceftriaxone. l Prophylaxis with rifampin, ciprofloxacin, or ceftriaxone for household and other close contacts
Neisseriaceae l Treatment and antimicrobial susceptibility – l GC used to use only penicillin. l l Resistant strains are emerging so lactamase testing should be done. For penicillin resistant strains or penicillin sensitive individuals substitute ceftriaxone or spectinomycin for penicillin (1 dose to treat GC) plus 7 days of doxycycline to treat possible coexisting C. trachomatis infection. Amoxicillin or ampicillin or Penicillin G plus probenecid can be used for uncomplicated cases MGC I. V. penicillin or chloramphenicol and erythromycin or ceftriaxone. l Prophylaxis with rifampin, ciprofloxacin, or ceftriaxone for household and other close contacts
 Treatment l Vaccines (tetravalent to polysaccharide capsular antigens A, C, Y, W 135) are available for the virulent types of MGC. Most human infections are due to types A, B, C, Y, and W 135. l They are given to those at risk, including college students living in dorms. l A group B vaccine consisting of OM antigens has been developed, but is not available in the United States. l
Treatment l Vaccines (tetravalent to polysaccharide capsular antigens A, C, Y, W 135) are available for the virulent types of MGC. Most human infections are due to types A, B, C, Y, and W 135. l They are given to those at risk, including college students living in dorms. l A group B vaccine consisting of OM antigens has been developed, but is not available in the United States. l


